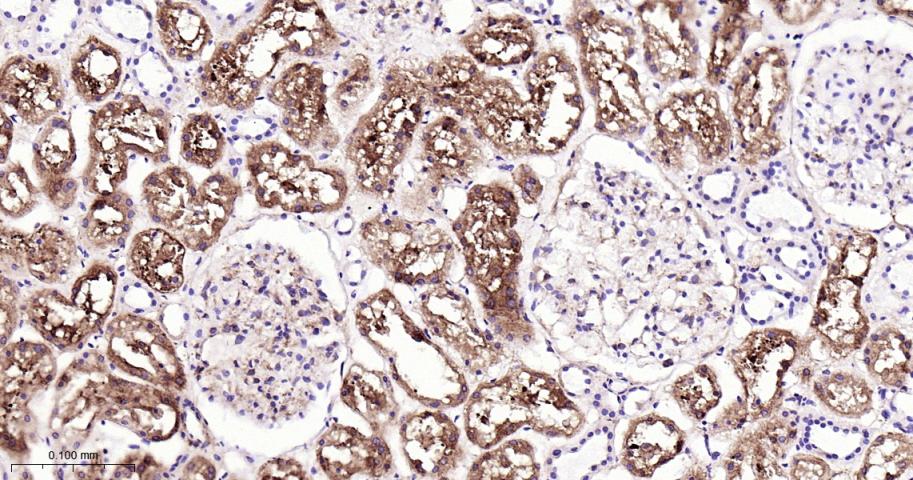
肺耐药相关蛋白重组兔单抗-bsm-61705R
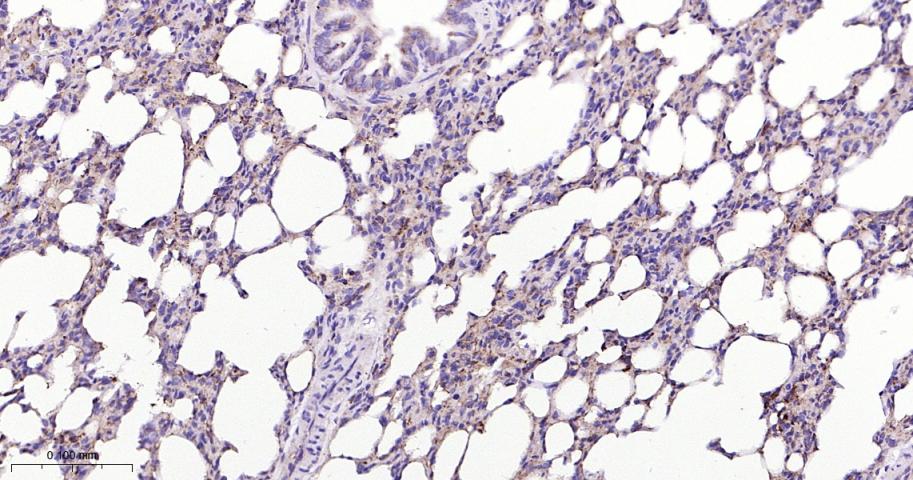
肺耐药相关蛋白重组兔单抗-bsm-61705R

LRP/MVP Recombinant Rabbit mAb (一抗) - WB,IHC-P,IHC-F,IF,Flow-Cyt | Bioss
Rrmab?兔单抗

货号:bsm-61705R
产品详情
相关标记
相关产品
相关文献
常见问题
概述
产品编号
bsm-61705R
产品类型
重组兔单抗、mIHC精品抗体
英文名称
LRP/MVP Recombinant Rabbit mAb
中文名称
肺耐药相关蛋白重组兔单抗
英文别名
LRP; VAULT1; 2310009M24Rik; MVP_BOVIN; MVP; MVP_HUMAN; Lung resistance-related protein; MVP_MOUSE; MVP_RAT;
抗体来源
Rabbit
免疫原
A synthesized peptide derived from human MVP: 1-55/893
亚型
IgG
性状
Liquid
纯化方法
affinity purified by Protein A
克隆类型
Recombinant
克隆号
11G10
理论分子量
99 kDa
检测分子量
108 kDa
储存液
10mM phosphate buffered saline(pH 7.4) with 150mM sodium chloride, 0.05% BSA, 0.02% Proclin300 and 50% glycerol.
研究领域
SWISS
Gene ID
保存条件
Store at 4℃ for short term. Store at -20℃ for long term. Avoid repeated freeze/thaw cycles.
注意事项
This product as supplied is intended for research use only, not for use in human, therapeutic or diagnostic applications.
数据库链接
产品介绍
LRP或称MVP(Major vault protein)为肺耐药相关蛋白。其耐药机制与该蛋白质参与细胞核-浆的运输有关。
他在正常细胞有广泛分布,对多种药物耐药的癌细胞呈过度表达,亦属多药耐药(MDR)中的一种表型,可表达于许多肿瘤组织中,阳性者预示对化疗不敏感,主要用于各种恶性肿瘤的研究。
他在正常细胞有广泛分布,对多种药物耐药的癌细胞呈过度表达,亦属多药耐药(MDR)中的一种表型,可表达于许多肿瘤组织中,阳性者预示对化疗不敏感,主要用于各种恶性肿瘤的研究。
背景资料
Required for normal vault structure. Vaults are multi-subunit structures that may act as scaffolds for proteins involved in signal transduction. Vaults may also play a role in nucleo-cytoplasmic transport. Down-regulates IFNG-mediated STAT1 signaling and subsequent activation of JAK. Down-regulates SRC activity and signaling through MAP kinases.

产品应用
| 应用 | 已检合格种属 | 预测种属 | 推荐稀释比例 |
|---|---|---|---|
| WB | Human, Mouse, Rat | 1:500-2000 | |
| IHC-P | Human, Mouse, Rat | 1:100-500 | |
| IHC-F | Human, Mouse, Rat | 1:100-500 | |
| IF | Human, Mouse, Rat | 1:100-500 | |
| Flow-Cyt | Human | Mouse, Rat | 1:50-100 |
交叉反应
交叉反应: Human, Mouse, Rat
相关产品
暂无相关产品
靶标
基因名
MVP
蛋白名
Major vault protein
亚基
The vault ribonucleoprotein particle is a huge (400 A x 670 A) cage structure of 12.9 MDa. It consists of a dimer of half-vaults, with each half-vault comprising 39 identical major vault protein (MVP) chains, PARP4 and one or more vault RNAs (vRNAs). Interacts with TEP1. Interacts with PTEN and activated MAPK1. The phosphorylated protein interacts with the SH2 domains of PTPN11 and SRC. Interacts with APEX1. May interact with ZNF540.
亚细胞定位
Cytoplasm. Nucleus, nuclear pore complex.
组织特异性
Present in most normal tissues. Higher expression observed in epithelial cells with secretory and excretory functions, as well as in cells chronically exposed to xenobiotics, such as bronchial cells and cells lining the intestine. Overexpressed in many multidrug-resistant cancer cells.
翻译后修饰
Phosphorylated on Tyr residues after EGF stimulation.
Dephosphorylated by PTPN11.
Dephosphorylated by PTPN11.
相似性
Contains 9 MVP (vault) repeats.
功能
Required for normal vault structure. Vaults are multi-subunit structures that may act as scaffolds for proteins involved in signal transduction. Vaults may also play a role in nucleo-cytoplasmic transport. Down-regulates INFG-mediated STAT1 signaling and subsequent activation of JAK. Down-regulates SRC activity and signaling through MAP kinases.
同靶标产品
相关文献
提示: 发表研究结果有使用 bsm-61705R 时请让我们知道,以便我们可以引用参考文章。作为回馈,资料提供者将获得我们送上的小礼品。